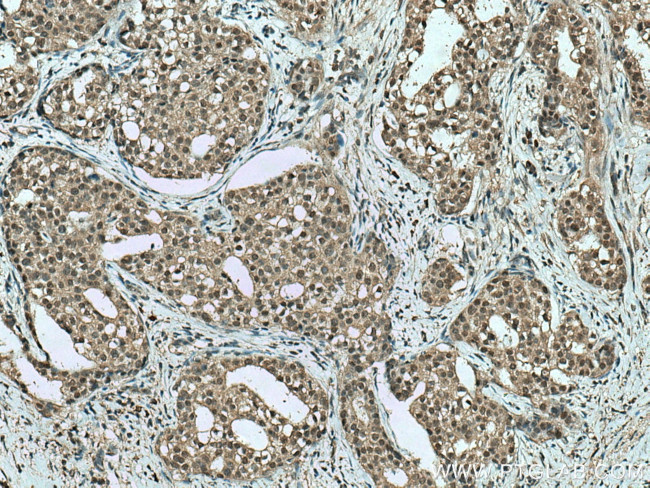
TRBP Antibody in Immunohistochemistry (Paraffin) (IHC (P))

Search
Proteintech
TRBP Monoclonal Antibody (1C9A10)
{{$productOrderCtrl.translations['antibody.pdp.commerceCard.promotion.promotions']}}
{{$productOrderCtrl.translations['antibody.pdp.commerceCard.promotion.viewpromo']}}
{{$productOrderCtrl.translations['antibody.pdp.commerceCard.promotion.promocode']}}: {{promo.promoCode}} {{promo.promoTitle}} {{promo.promoDescription}}. {{$productOrderCtrl.translations['antibody.pdp.commerceCard.promotion.learnmore']}}
产品信息
66792-1-IG
种属反应
宿主/亚型
分类
类型
克隆号
抗原
偶联物
形式
浓度
纯化类型
保存液
内含物
保存条件
运输条件
产品详细信息
Immunogen sequence: MSEEEQGSG TTTGCGLPSI EQMLAANPGK TPISLLQEYG TRIGKTPVYD LLKAEGQAHQ PNFTFRVTVG DTSCTGQGPS KKAAKHKAAE VALKHLKGGS MLEPALEDSS SFSPLDSSLP EDIPVFTAAA AATPVPSVVL TRSPPMELQP PVSPQQSECN PVGALQELVV QKGWRLPEYT VTQESGPAHR KEFTMTCRVE RFIEIGSGTS KKLAKRNAAA KMLLRVHTVP LDARDGNEVE PDDDHFSIGV GSRLDGLRNR GPGCTWDSLR NSVGEKILSL RSCSLGSLGA LGPACCRVLS ELSEEQAFHV SYLDIEELSL SGLCQCLVEL STQPATVCHG SATTREAARG EAARRALQYL KIMAGSK (1-366 aa encoded by BC005860)
靶标信息
TRBP belongs to the family of dsRNA-binding proteins. It consists of highly conserved 2 dsRNA-binding domains and C-terminal basic region. It is a unique cellular protein capable of binding to HIV-TAR RNA and stimulates expression of HIV-1 long terminal repeats. It also inhibits the host antiviral and anti-proliferative mechanisms by directly binding to IFN-regulated dsRNA-dependent protein kinase (PKR). TRBP associates with Ago2 protein and forms an integral component of Dicer-containing complex. It has a role in micro RNA processing and in RISC assembly. Other functions of TRBP include promoting cellular growth and tumorigenesis.
仅用于科研。不用于诊断过程。未经明确授权不得转售。
生物信息学
蛋白别名: RISC-loading complex subunit TARBP2; TAR (HIV) RNA binding protein 2; TAR (HIV) RNA-binding protein 2; TAR (HIV) RNA-binding protein TRBP1; TAR (HIV-1) RNA binding protein 2; TAR RNA binding protein 2; TAR RNA-binding protein 2; TARBP2; trans-activation responsive RNA-binding protein; Trans-activation-responsive RNA-binding protein
基因别名: LOQS; TARBP2; TRBP; TRBP1; TRBP2
UniProt ID: (Human) Q15633
Entrez Gene ID: (Human) 6895